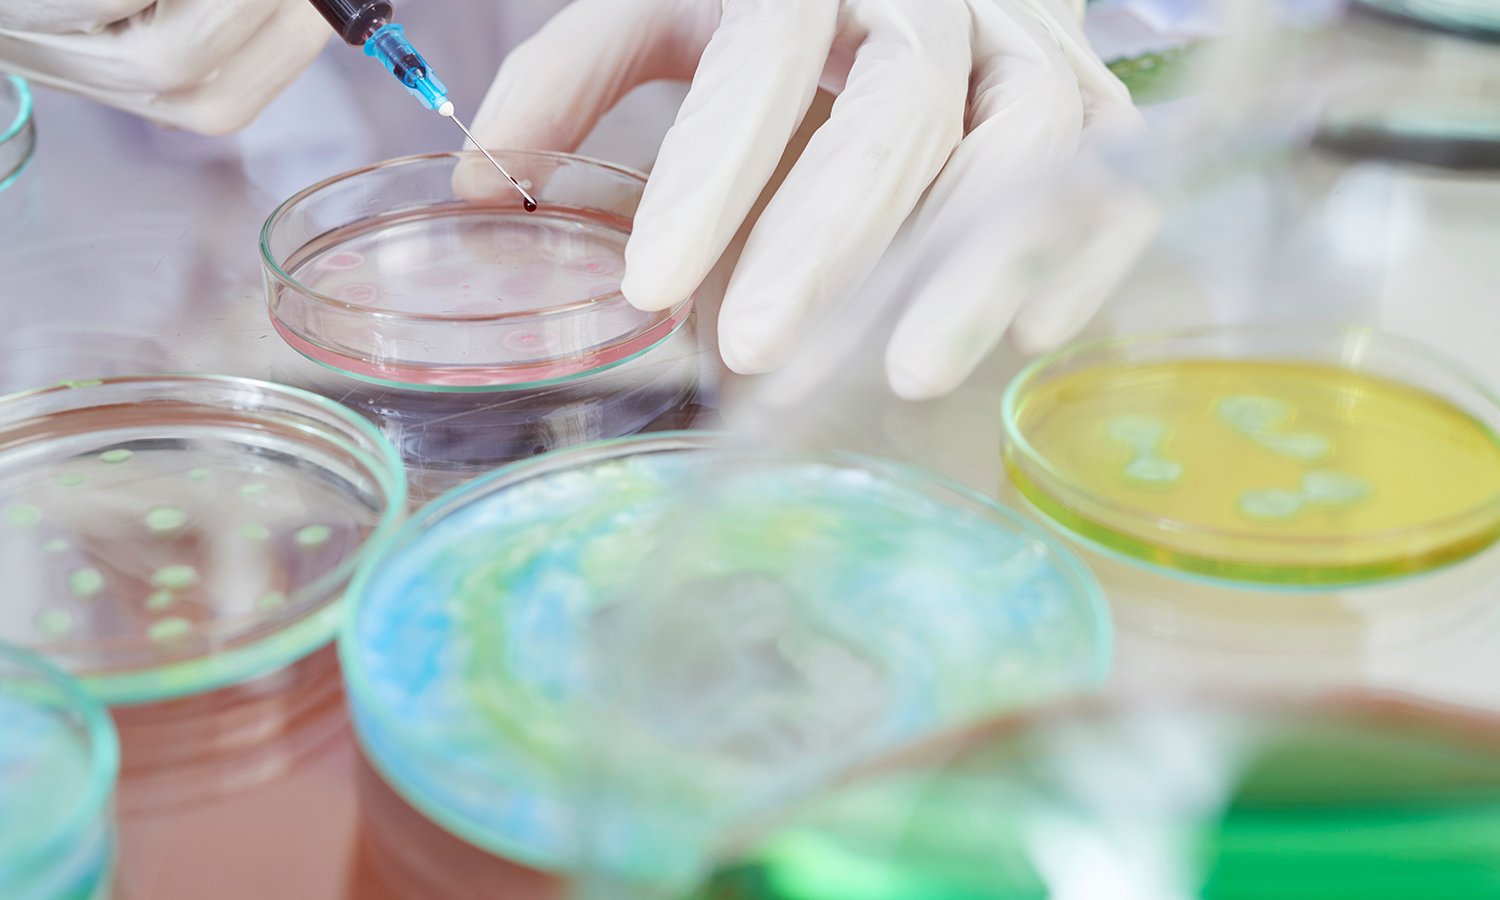
高效液相色譜法檢測黃芩中黃芩苷

Application Center
應用中心
高效液相色譜法檢測錦燈籠中木犀草苷
本文參照2020版《中國藥典》,采用全多孔色譜柱Alphasil VC-C18,對錦燈籠供試品進行分析,結果顯示,錦燈籠中目標峰峰形良好,木犀草苷目標峰理論塔板數(shù)大于3000,符合《中國藥典》要求。本方案可為錦燈籠中木犀草苷的測定提供參考。 2023-08-04
高效液相色譜法檢測黃芩中黃芩苷
本文參照2020版《中國藥典》,采用全多孔色譜柱Alphasil VC-C18,對黃芩供試品進行分析,結果顯示,黃芩中目標峰峰形良好,黃芩苷目標峰理論塔板數(shù)大于2500,符合《中國藥典》要求。本方案可為黃芩中黃芩苷的測定提供參考。 2023-07-28
高效液相色譜法檢測黃蜀葵花中金絲桃苷
本文參照2020版《中國藥典》,采用全多孔色譜柱Alphasil VC-C18,對黃蜀葵花供試品進行分析,結果顯示,黃蜀葵花中目標峰峰形良好,金絲桃苷目標峰理論塔板數(shù)大于10000,符合《中國藥典》要求。本方案可為黃蜀葵花中金絲桃苷的測定提供參考。 2023-07-21
高效液相色譜法檢測化橘紅中柚皮苷
本文參照2020版《中國藥典》,采用全多孔色譜柱Alphasil VC-C18,對化橘紅供試品進行分析,結果顯示,化橘紅中目標峰峰形良好,柚皮苷目標峰理論塔板數(shù)大于1000,符合《中國藥典》要求。本方案可為化橘紅中柚皮苷的測定提供參考。 2023-06-25
高效液相色譜法檢測胡椒中胡椒堿
本文參照2020版《中國藥典》,采用全多孔色譜柱Alphasil VC-C18,對胡椒供試品進行分析,結果顯示,胡椒中目標峰峰形良好,胡椒堿目標峰理論塔板數(shù)大于1500,符合《中國藥典》要求。本方案可為胡椒中胡椒堿的測定提供參考。 2023-06-16
高效液相色譜法檢測厚樸中厚樸酚與和厚樸酚
本文參照2020版《中國藥典》,采用全多孔色譜柱Alphasil VC-C18,對厚樸供試品進行分析,結果顯示,厚樸中目標峰峰形良好,厚樸酚目標峰理論塔板數(shù)大于3800,符合《中國藥典》要求。本方案可為厚樸中厚樸酚與和厚樸酚的測定提供參考。 ? 2023-06-09
高效液相色譜法檢測何首烏中2,3,5,4'-四羥基二苯乙烯-2-O-β-D-葡萄糖苷
本文參照2020版《中國藥典》,采用全多孔色譜柱Alphasil VC-C18,對何首烏供試品進行分析,結果顯示,何首烏中目標峰峰形良好,2,3,5,4'-四羥基二苯乙烯-2-O-β-D-葡萄糖苷目標峰理論塔板數(shù)大于2000,符合《中國藥典》要求。本方案可為何首烏中2,3,5,4'-四羥基二苯乙烯-2-O-β-D-葡萄糖苷的測定提供參考。 2023-06-02
高效液相色譜法檢測合歡花中槲皮苷
本文參照2020版《中國藥典》,采用全多孔色譜柱Alphasil VC-C18,對合歡花供試品進行分析,結果顯示,合歡花中目標峰峰形良好,槲皮苷目標峰理論塔板數(shù)大于3000,符合《中國藥典》要求。本方案可為合歡花中槲皮苷的測定提供參考。 2023-05-25
高效液相色譜法檢測枸杞子中甜菜堿
本文參照2020版《中國藥典》,采用全多孔色譜柱Alphasil VC-NH2,對枸杞子供試品進行分析,結果顯示,枸杞子中目標峰峰形良好,甜菜堿目標峰理論塔板數(shù)大于3000,符合《中國藥典》要求。本方案可為枸杞子中甜菜堿的測定提供參考。 2023-05-12
高效液相色譜法檢測桂枝中桂皮醛
本文參照2020版《中國藥典》,采用全多孔色譜柱Alphasil VC-C18,對桂枝供試品進行分析,結果顯示,桂枝中目標峰峰形良好,桂皮醛目標峰理論塔板數(shù)大于3000,符合《中國藥典》要求。本方案可為桂枝中桂皮醛的測定提供參考。 2023-05-06
高效液相色譜法檢測貫葉金絲桃中金絲桃苷
本文參照2020版《中國藥典》,采用全多孔色譜柱Alphasil VC-C18,對貫葉金絲桃供試品進行分析,結果顯示,貫葉金絲桃中目標峰峰形良好,金絲桃苷目標峰理論塔板數(shù)大于3000,符合《中國藥典》要求。本方案可為貫葉金絲桃中金絲桃苷的測定提供參考。 2023-04-21
高效液相色譜法檢測葛根中葛根素
本文參照2020版《中國藥典》,采用全多孔色譜柱Alphasil VC-C18,對葛根供試品進行分析,結果顯示,葛根中目標峰峰形良好,葛根素目標峰理論塔板數(shù)大于4000,符合《中國藥典》要求。本方案可為葛根中葛根素的測定提供參考。 2023-04-07感謝您對華譜產品的關注與信任,如您在瀏覽網站期間有任何疑問或產品有任何異常情況,請留言給我們或致電我司。
客戶服務熱線 :400-108-7908,
我們將第一時間與您取得聯(lián)系,祝您和家人幸福安康!